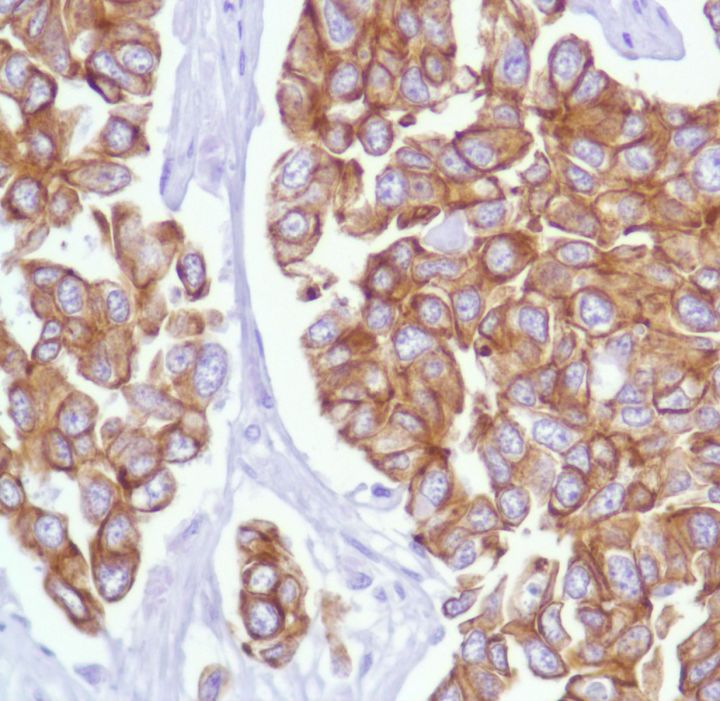

Keratin 18 (SP69)
Cytokeratin 18 is an acidic keratin which is found primarily in non-squamous epithelia and is present in a majority of adenocarcinomas and ductal carcinomas but not in squamous cell carcinomas. Cytokeratin 18 exists in combination with Cytokeratin 8, a basic keratin. Hepatocellular carcinomas express only Cytokeratins 8 and 18.
....Related Files